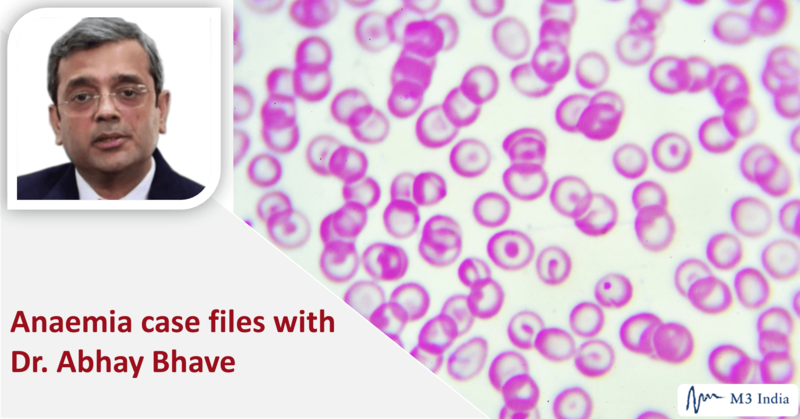

Anaemia case files with Dr. Abhay Bhave
M3 India Newsdesk Aug 28, 2019
There are various forms of anaemia and each requires a specific approach to its diagnosis and treatment. Haematology expert Dr. Abhay Bhave in his webinar recently shared with us insights and tips on identifying the causes of anaemia, selecting tests for diagnosis and choosing the right treatment for patients. Here is an excerpt from it.
Dr. Abhay Bhave mentions that correcting anaemia calls for a stepwise approach.
- To arrive at a diagnosis, one should understand the patient’s diet, symptoms, patient's and family’s medical history, and study the different lab test parameters
- As for the treatment and choice of therapy, it is essential to study the Clinical Pathology Correlation (CPC) and determine the therapy in accordance with all of the above
- It doesn’t end there; assessment of the response to therapy is the next step and if needed, corrective treatment should follow
- The approach to treatment also includes ensuring the condition does not relapse and your treatment is able to provide a good quality of life to your patient
Here are a few case studies from Dr. Bhave's webinar that elaborate on the various types of anaemic conditions and the methodical approach used in diagnosis and treatment.
Case 1: CPC can save the patient unnecessary tests and help the clinician arrive at a diagnosis
Patient presentation
A 54-year old male, badminton player who plays the sport thrice a week undergoes regular check-ups and has had no complaints. However, one such routine check-up shows an abnormal CBC count, a haemoglobin of 7, a WBC count of 3300 and 28,000 platelets. The man did not have any symptoms to report.
Investigation
He is first referred for a bone marrow examination and was advised an urgent admission to identify the cause. A typical knee-jerk reaction for a physician is to repeat the CBC test. When the test was repeated, nothing abnormal was found. However, it was discovered that the blood sample collected for the first test had clotted, and that could have led to the abnormal results.
Remarks
CPC involves studying the lab reports in conjunction with the patient’s clinical history and behaviour. Keeping CPC in mind, the patient was asked to only perform a CBC test and the result was a normal count.
Case 2: A methodical approach to diagnosis
Patient presentation
A 25 year-old patient complaining of fatigue has a haemoglobin level of 8, a normal WBC count with a normal differential and a normal platelet count. With only so much information, we can say the diagnosis is anaemia.
There is also no organomegaly, no lymphadenopathy or icterus, no haemolysis and probably nothing more sinister in terms of a long-ranging process.
Can you make a diagnosis without a CBC report?
The peripheral smear in this patient showed lots of small cells with a huge amount of pallor in the centre. These are Hypochromic Microcytic cells. The conclusion is Iron Deficiency Anaemia (IDA). Iron deficiency is common in our country, plus the feedback on medical history and physical examination is good. So, yes, here the diagnosis was possible without a CBC.
But given a CBC report, what should you look at?
The answer is the indices: the MCV, MCH, MCHC and the RBC count, all of which are low. With everything low, including haemoglobin, this is mostly IDA. So the diagnosis is established, but what is the cause behind it?
With Hypochromic Microcytic in mind, we need to play with five differential diagnoses to see if we can arrive at the correct diagnosis; iron deficiency, beta or alpha Thalassemia, sideroblastic anaemia, anaemia of chronic disease and lead exposure. All can be causes for Hypochromic Microcytic Anaemia. So, with the knowledge of these indices, you can raise questions to be able to differentiate between these and come to a proper conclusion.
How would one differentiate between these?
- Do a serum ferritin, and if the ferritin level is low, this is iron deficiency unless proved otherwise.
- Don’t do haemoglobin electrophoresis when there is an ongoing iron deficiency. Treat the iron deficiency first, then do the haemoglobin electrophoresis to pick up beta Thalassemia. It does not pick up alpha Thalassemia.
- If the ferritin comes normal, do an HB electrophoresis to diagnose beta Thalassemia. If it is not that, do a DNA PCR on the peripheral blood to get a diagnosis of alpha Thalassemia.
- Sideroblastic Anaemia and anaemia of chronic diseases are picked up on a bone marrow examination. Conducting iron staining can help pick up ring sideroblast in the erythroid of the bone marrow.
- If there is a history of being exposed to medication that contained lead, then do a lead level and prove the diagnosis that it indeed was higher.
- If you get a slide that shows tear drop cells, it is indicative of Beta Thalassemia trait rather than iron deficiency. A trained eye will be able to make out even subtle changes much faster, and without the CBC.
- Many a times an HB electrophoresis may not give you the classical increase in haemoglobin A2, which is diagnostic of Beta Thalassemia. Then you can diagnose Beta Thalassemia on the basis of HB electrophoresis, where haemoglobin A2 is above 3.5.
- Sometimes, there are some mutations, which do not have such a high rise in A2, they are called Silent A2 or Normal A2 Thalassemia. So, if a patient who is Hypochromic Microcytic, especially where the MCB is less than 72 and MCH is less than 27, look for an underlying Thalassemia.
- You can do a genetic test to pick up a Silent Beta Thalassemia. If a woman has a Beta Thalassemia and the husband also has a Beta Thalassemia trait, then you can prevent the birth of a Major Child in these patients.
Simply put, look at the ferritin. It is usually normal in Thalassemia patients, decreased in patients with iron deficiency, and increased in patients, who have Anaemia of Chronic Disease.
Practice points
- Look at five things: S low haemoglobin, low MCB, low MCH, low MCHC and a low RBC count. When all five are low, it is mostly IDA. It is possible to treat these patients with iron therapy.
- If the patients don’t respond to this therapy, additional investigations can be performed.
- If there is anaemia, low haemoglobin, low MCB, and low MCH, then the diagnosis is Hypochromic Microcytic Anaemia. But if MCHC is normal and the RBC count is raised, this could be Beta Thalassemia or even Alpha Thalassemia. Do the relevant test to arrive at a conclusion.
Unfortunately in India, most of the times we get a mixed picture, where there is a combination of iron deficiency and Thalassemia. Therefore, we will have to do the iron deficiency test first, followed by a test for Thalassemia. It is would be better not to rush into Thalassemia tests because if the patient has a normal report, it remains as normal throughout their life and therefore, one may miss Thalassemia.
Can a Thalassemia patient be given iron therapy?
We are told not to give iron therapy but if there is iron deficiency proven in a Beta Thalassemia trait. The patient must be given iron therapy to improve their erythropoiesis and haemoglobin.
Case 3: Steps for correcting iron deficiency anaemia in a patient with poor dietary habits
Patient presentation
A 25-year-old patient complains of fatigue. The haemoglobin is 8, the WBC count is normal and the platelets are normal, too. MCV remains low and he has poor dietary habits. A poor diet means this is nutritional IDA.
Taking oral iron therapy brings along lots of GI side effects, so it is better to give such a patient just one tablet of iron per day, after food. Once the patient begins iron therapy, continue it for a period of four to six months, in order to replete the stores of ferritin in the body. With this therapy and an improvement in diet, the patient should feel better in the next few months to years.
As less as 37.5 mg of elemental iron per day is enough. One doesn't have to rush into giving 350 and 360 mg of iron every day. If the compliance is poor, patients don’t take the prescribed iron medicine and can return with the same iron deficiency problem.
An insight into iron absorption with vegetarian and non-vegetarian diet:
- Taking in iron through a non-vegetarian diet, which is in the form of heme iron, enables faster absorption. It goes into the mucosa, enters the system through ferroportin into the blood, goes for the erythron to produce red cells, and excess of it goes to the liver as hepcidin.
- Iron present in a vegetarian diet converts from its ferric form to the ferrous form first. Then it enters through a different route into the mucosa, goes through the ferroportin, enters the circulation, gets converted to the ferric form again, goes into the blood, then erythron, produces red cells, and the excess goes to the liver and is stored as hepcidin.
Note that non-vegetarian food tends to get better absorbed, while vegetarian food needs a lot of effort to convert itself into an absorbable form. And there are many systems, which work inside the mucosa, therefore, if there is something wrong with the mucosa, absorption will be poor. Even if the patient were to take oral iron, he may not be able to come up trumps in term of getting haemoglobin to rise.
A new factor, hepcidin has been identified to play an important role. Hepcidin regulates the quantity of iron that enters the blood. If hepcidin is high, it reduces the amount of iron entering the blood and excess iron gets stored as mucosal ferritin. At the time of denudation, it gets shed along with the epithelial cells, so that excess iron does not enter the body. Nature’s mechanism to control iron with a negative feedback through hepcidin is simply brilliant!
Opting for Iron Therapy
There are several salts of oral iron, such as ferrous fumarate, ascorbate, calcium citrate, carbonyl iron and many others. The best iron for the patient is the one the patient can swallow and swallow every day compliantly. It’s very important to identify what the patient is comfortable with. Despite this, we often see that patients cannot tolerate iron because of the GI side effects it brings along and of the toxicity, which is because of the release of iron into the gastric acids. Needless to say, this gives rise to problems and a situation such as this, leaves doctors with no choice but to use parenteral iron therapy.
When to use parenteral iron therapy and for whom?
- Use parenteral iron therapy whenever there is an urgent need to quickly bring up the haemoglobin level. It works best in pregnancies, especially in the second and third trimesters or in a post-operative recovery, where one would prefer not to give transfusion and rather prescribe iron therapy because blood transfusions negatively impact the outcome in patients who have undergone surgery.
- For patients of renal disease, who are on dialysis, giving erythropoietin along with parenteral iron makes a lot of difference.
- For those patients, who for religious reasons do not want blood transfusions, parenteral iron may help bring up the haemoglobin to a level, at which it is safe enough for them to undergo surgery.
- One can also do autologous blood collection and then go for transfusion, subsequently.
Case 4: Diagnosing without knowing the characteristics of the anaemia
Patient presentation
A 25 year-old patient complains of fatigue but has normal haemoglobin, white cells and platelets, no organomegaly. Everything is fine but we do not know of the characteristics of this anaemia. The indices show an MCV of 121 and the RBC count is low so the problem at hand is Macro.
- For the same haemoglobin, now there is a different absolute value to it, the MCV is 121. So it is either a B12 deficiency, folate deficiency, or a bone marrow disorder such as, Myelodysplasia.
- Other possible causes include Autoimmune Haemolytic Anaemia and other endocrine problems such as, hypothyroidism or alcoholism-related liver disease.
Practice pointers
Usually, if the MCV goes above 120, chances are it is B12 deficiency. An MCV, which is between 100 and 110 or 115 may not always be a B12 deficiency. So the MCV value might actually lead to something other than a B12 deficiency. It could be a bone marrow disorder or haemolysis. Vitamin B12 level and a folate level tests can be done to prove the diagnosis of either of the deficiencies. If the levels are normal, then consider a Direct Coombs Test to figure out if it is haemolysis and an LDH, which will be high in patients with haemolysis.
- When B12 is low but LDH is normal, it indicates that this is not contributory to anaemia
- But, if B12 is low and LDH is high, that B12 level is contributory to anaemia
If it is Pernicious Anaemia, then there is a problem in the stomach. This patient tends to get B12 deficiency again and again. Doing an endoscopy to show gastric achlorhydria and doing a biopsy to show gastric atrophy helps. Repeat endoscopies as and when needed because these patients, in the future, can develop malignancies in the stomach and endoscopies would help prevent the development of a sinister disease.
If everything is fine, a bone marrow examination may have to be done to get answers about other causes of Macrocytosis, which are not B12 or folate deficiencies. These could be Myelodysplastic Syndrome, Aplastic Anaemia, and other bone marrow failure syndromes, which may come in the garb of a B12 deficiency but are not actually a B12 deficiency. If B12 therapy is given to such patients, they will not show any benefit. Hence, doing B12 and LDH tests are important.
There are some laboratories, which perform tests for the active form of B12 and that also helps. Sometimes, the B12 level is low but the active is normal, and sometimes the B12 level is normal, and active level which is low.
The peripheral smear in this patient showed beautiful macrocytes with macro ovalocytes, with Howell Jolly bodies inside it. A CBC report is not needed for this. This is B12 deficiency or folate deficiency, unless proved otherwise. Treat such patients with therapy and then do a CBC to assess the response to therapy.
When is transfusion necessary?
The WHO states that transfusion should not be used indiscriminately. So prescribe it only for conditions where no other treatment is possible. Please do not resort to quick-fix haematology by giving transfusions for anaemia, because that not only lasts for a short period of time, but it also comes with additional problems like infections, immunodeficiencies and other immune-related problems.
Which types of patients may have no other option except transfusion?
- Active bleeders
- Those with active haemolysis like G6PDs and autoimmune haemolytic anaemia
- In older patients with a cardiac compromise and plummeting haemoglobin, and
- Refractory anaemia such as, Aplastic Anaemia, Myelodysplastic Syndrome or Beta Thalassemia Majors
Give every step, right from diagnosis to post-treatment assessment, equal importance to ensure your patient benefits from your consultation. Every anaemic patient deserves a good quality of life that anaemia correction can give them and we can help them achieve that.
Disclaimer
This document is a transcription of a portion of the webinar, produced for audience with bandwidth limitations that could possibly restrict them from viewing the video. While it is believed to be accurate, it is not warranted to be so. Divergence in format is to be expected.
The views and opinions expressed in this article are those of the author's and do not necessarily reflect the official policy or position of M3 India.
-
Exclusive Write-ups & Webinars by KOLs
-
Daily Quiz by specialty
-
Paid Market Research Surveys
-
Case discussions, News & Journals' summaries